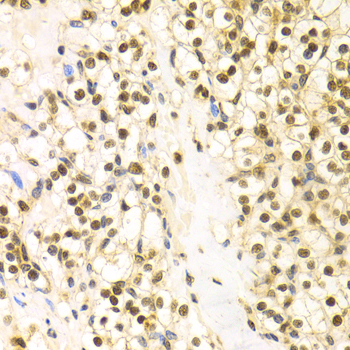
A1104: image 2

For quotations, please use our online quotation form, and you may also contact us by
sales@neoscientific.com
+1-888.733.6849
+1-617.299.7367 (Int’l)
+1-888.733.6849
+1-617.299.7367 (Int’l)
| Reactivity | Human Mouse Rat |
| Tested applications | WB IHC IF |
| Recommended Dilution | WB 1:500 - 1:2000 IHC 1:50 - 1:200 IF 1:20 - 1:100 |
| Calculated MW | 39kDa |
| Observed MW | Refer to Figures |
| Immunogen | Recombinant protein of human BAG1 |
| Storage Buffer | Store at -20℃. Avoid freeze / thaw cycles. Buffer: PBS with 0.02% sodium azide, 50% glycerol, pH7.3. |
| Concentration | b |
| Synonym | Bag 1;BAG1;BAG1S;HAP;BAG1M;BAG1L specific;RAP46; |

Western blot analysis of extracts of various cell lines, using BAG1 antibody.
Immunohistochemistry of paraffin-embedded human kidney cancer using BAG1 antibody at dilution of 1:100 (x400 lens).

Immunohistochemistry of paraffin-embedded human kidney injury using BAG1 antibody at dilution of 1:100 (x400 lens).

Immunohistochemistry of paraffin-embedded human esophageal cancer using BAG1 antibody at dilution of 1:100 (x400 lens).

Immunofluorescence analysis of U2OS cell using BAG1 antibody. Blue: DAPI for nuclear staining.
Bag1 belongs to the Bcl-2 associated athanogene (BAG) family of multifunctional proteins and was the first of six related proteins isolated from humans (1,2). This widely expressed protein interacts with a number of signaling molecules (including Bcl2, HGF receptor and Raf1) as it regulates signaling molecules in pathways involving cell survival, growth and differentiation. The most common role played by Bag1 protein is as an inhibitor of proteins favoring apoptosis (2-4). Bag1 also plays a role in Raf1 signaling and binds DNA as a transcription activator (4). Bag1 protein is a well-characterized inhibitor of its binding partner HSP70 (5). A conserved carboxy-terminal BAG domain within Bag1 interacts with the ATPase domain of HSP70 to negatively regulate heat shock protein chaperone activity (6,7). The multiple isoforms of Bag1 protein generated from a single transcript share a common ubiquitin homology domain and a carboxy-terminal Hsp70 binding region but differ in length and cellular localization. The 50 kDa long (Bag1-L) isoform also contains a nuclear localization signal and is often found in the nucleus where it activates transcription. The 46 kDa intermediate (Bag1-M) isoform is found mainly in the cytoplasm but can also translocate to the nucleus when associated with other proteins. The shorter 29-33 kDa isoforms (Bag1-S, Bag-1) isoforms are found primarily in the cytoplasm (8). High expression of the anti-apoptotic Bag1 protein correlates with increased survival in patients with particular forms of cancer, leading researchers to study possible therapeutic roles for Bag1 protein (9)
N/A